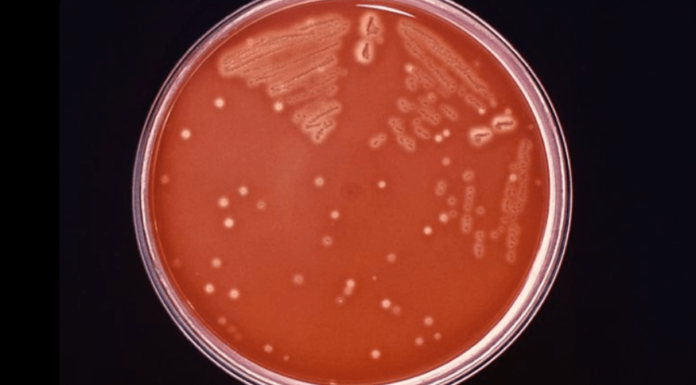

Pelo menos três pessoas morreram nos estados americanos de Connecticut e Nova York depois de contrair uma bactéria carnívora rara que pode ser encontrada em águas quentes e salobras ou mariscos crus, confirmaram autoridades na quarta-feira (16).
Duas pessoas em Connecticut foram infectadas com Vibrio vulnificus e morreram depois de nadar em dois locais separados em Long Island Sound, de acordo com Christopher Boyle, diretor de comunicações do Departamento de Saúde Pública do estado.
Uma terceira pessoa foi infectada em julho depois de comer ostras cruas de um estabelecimento fora do estado, de acordo com o Departamento de Saúde Pública. Todos os três tinham entre 60 e 80 anos, de acordo com o departamento.
A bactéria também foi detectada em um indivíduo que morreu em Long Island, anunciou a governadora Kathy Hochul na quarta-feira (16). As autoridades ainda estão investigando a morte no condado de Suffolk para determinar se a bactéria foi encontrada nas águas de Nova York ou em outro lugar, de acordo com o comunicado à imprensa.
Vibrio vulnificus vem da mesma família da bactéria que causa a cólera.
Um caso leve de vibriose de infecção bacteriana pode causar feridas na pele, bolhas, abscessos e úlceras. Geralmente inclui calafrios, febre, diarreia, dor de estômago e possivelmente vômitos. Em casos mais graves, as pessoas podem desenvolver septicemia.
O caso é mais comum para aqueles com condições de saúde cujos sintomas não se manifestam imediatamente, como particularmente em doenças hepáticas, câncer, diabetes, HIV ou outras doenças que suprimem o sistema imunológico.
Qualquer pessoa pode contrair vibriose, mas pessoas com feridas abertas, como cortes ou arranhões, piercings recentes ou tatuagens novas, devem evitar expor a pele à água do mar quente em ambientes costeiros ou devem cobrir a área com um curativo à prova d’água, diz o comunicado à imprensa.
Os médicos dizem que é importante procurar tratamento rapidamente em de infecção de pele após uma possível exposição à bactéria.
Vibrio vulnificus causa cerca de 80.000 doenças e 100 mortes nos Estados Unidos todos os anos, de acordo com os Centros de Controle e Prevenção de Doenças dos EUA.
Cautela
Autoridades de Connecticut e Nova York estão aconselhando as pessoas a tomarem precauções antes de consumir ostras cruas ou serem expostas a água salgada ou salobra.
“As pessoas devem considerar o risco potencial de consumir ostras cruas e exposição à água salgada ou salobra e tomar as devidas precauções”, disse Manisha Juthani, comissário do Departamento de Saúde Pública de Connecticut, em comunicado à imprensa em 28 de julho.
“Particularmente durante os meses mais quentes do verão, é mais provável que as bactérias cresçam demais e contaminem os mariscos crus.”
O governador de Nova York ecoou as orientações na quarta-feira.
“Embora rara, a bactéria vibrio infelizmente chegou a esta região e pode ser extraordinariamente perigosa”, disse Hochul.
“À medida que investigamos mais, é fundamental que todos os nova-iorquinos permaneçam vigilantes e tomem precauções responsáveis para manter a si mesmos e seus entes queridos seguros, incluindo a proteção de feridas abertas da água do mar e para aqueles com sistema imunológico comprometido, evitando mariscos crus ou mal cozidos que podem transmitir as bactérias.”
Connecticut monitora rotineiramente as áreas de coleta de ostras em todo o estado quanto aos níveis de vibrio no verão e, desde 2014, o estado aumentou seus requisitos para a coleta de ostras.
Em parte, os colhedores de ostras são obrigados a deixar ostras na sombra enquanto estiverem em navios e em áreas de alto risco, e ostras colhidas devem ser colocadas em um recipiente com gelo para reduzir a temperatura interna abaixo de 10 °C dentro de três horas após a coleta, de acordo com o estado Departamento de Agricultura. (com informações CNN)